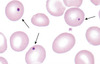

S6) The Spleen, White Blood Cells & Cytopenia Flashcards
Where is the spleen located?
The spleen is located in the left upper quadrant of the abdomen

Describe the contents and structure of the spleen
- Red pulp – sinuses lined by endothelial macrophages and cords
- White pulp – similar structure to lymphoid follicles

Blood enters the spleen via the splenic artery.
Where do the different blood cells go?
- White cells and plasma preferentially passing through the white pulp
- Red cells preferentially passing through the red pulp
Explain how the spleen acts as a blood filter
- The red pulp removes old red cells and metabolises the haemoglobin
- The white pulp synthesises antibodies and removes antibody-coated bacteria and blood cells
Describe four situations where splenomegaly is usually seen
- Increased workload e.g. haemolytic anaemia (increased number of defective red cells)
- Congestion e.g. portal hypertension (increases back pressure)
- Infiltration by leukaemias and lymphomas
- Expansion due to accumulation of metabolic waste products
What is hyposplenism?
Hyposplenism is the term used to describe reduced splenic function and is associated with an increased risk of overwhelming sepsis
What are some causes of hyposplenism?
- Underlying diseases which destroy spleen tissue e.g. sickle-cell disease, coeliac disease
- Splenic rupture from trauma/tumour
A blood film from a patient with hyposplenism will typically reveal which structures?
Howell-Jolly bodies which are basophilic nuclear remnants in circulating erythrocytes
Explain how Howell-Jolly bodies are formed and why they are a good indicator of splenic function
- During erythropoiesis, erythroblasts normally expel their nuclei but in some cases a small portion of DNA remains
- Normally such cells would be removed by the spleen so the presence of Howell-Jolly bodies is a good indicator of reduced splenic function
The term cytopenia is used to describe a reduction in the number of blood cells. It takes a number of forms.
Identify and describe them
- Low red cell count = anaemia
- Low white blood = leucopenia
- Low neutrophil count = neutropenia
- Low platelet count = thrombocytopenia
- Low red cells, white cells, and platelets = pancytopenia
An increase in the number of blood cells is signified by the suffix cytosis or philia. This takes a number of forms.
Identify and describe them
- High red cell count = erythrocytosis
- High white blood = leucocytosis
- High neutrophil count = neutrophilia
- High lymphocyte count = lymphocytosis
- High platelet count = thrombocytosis
Unlike erythrocytes and platelets, all leucocytes have a nucleus.
How can they be classified?
- By their structure (granulocytes and agranulocytes)
- By their cell lineage (myeloid cells and lymphoid cells)
According to their morphological and functional characteristics, these broad categories can be further divided into the five main types of leucocyte.
Identify these
- Basophils (granulocytes and myeloid)
- Neutrophils (granulocytes and myeloid)
- Eosinophils (granulocytes and myeloid)
- Monocytes (agranular and myeloid)
- Lymphocytes (agranular and lymphoid)
Describe the different staining characteristics of granulocytes with H&E
- Basophils stain dark blue
- Eosinophils stain bright red
- Neutrophils stain a neutral pink

What are neutrophils and what do they do?
- Neutrophils are the most abundant type leucocyte and are an essential part of the innate immune system
- They are short-lived and highly mobile cells that can migrate into tissues to destroy pathogens

How is neutrophil function controlled?
Neutrophil function is controlled by the glycoprotein granulocyte-colony stimulating factor (G-CSF)
What is the effect of G-CSF on neutrophils?
- Increases their production in bone marrow
- Decreases their maturation time
- Enhances chemotaxis and phagocytosis
Identify some possible causes of neutrophilia (a high number of neutrophils in blood)?
- Bacterial infection
- Acute inflammation
- Drugs e.g. prednisone
- Malignancy
- Myeloproliferative diseases
- Acute haemorrhage
Neutropenia is often seen in life threatening bacterial / fungal infection.
Identify some causes of this
- Increased removal due to immune destruction or splenic pooling
- Reduced production due to B12/folate deficiency, infiltration by malignancy or fibrosis, aplastic anaemia, drugs, viruses
What are monocytes and what do they do?
- Monocytes are the largest type of leucocyte
- They circulate in the blood for ~1-3 days before moving into tissues and differentiating into tissue resident macrophages or dendritic cells

Monocytes, macrophages and dendritic cells serve three main functions.
What are these?
- Phagocytosis
- Antigen presentation
- Cytokine production
What are the possible causes of monocytosis?
- Chronic inflammatory conditions e.g. rheumatoid arthritis, lupus (SLE), Crohn’s disease,ulcerative colitis
- Chronic infections e.g. tuberculosis, myeloproliferative disorders, malignancies
What are eosinophils?
Eosinophils are leucocytes which have a bi-lobed nucleus and an important role in immune responses to multicellular parasites (helminths)

What do eosinophils do?
Release of their granular contents which contains enzymes, ROS, various leukotrienes and cytokines aids in the destruction and subsequent phagocytosis of invading pathogens
What are the possible causes of eosinophilia?
- Allergic diseases (asthma, eczema, hay fever)
- Drug hypersensitivity (penicillin)
- Parasitic infection (helminths)
- Lymphoma, leukaemia & myeloproliferative conditions
What are basophils?
Basophils are the least numerous leucocyte and contain large cytoplasmic granules which may obscure the cell nucleus when stained in microscopy

What are the possible causes of basophilia?
- Inflammatory conditions e.g. ulcerative colitis, rheumatoid arthritis
- Immediate hypersensitivity reactions to drugs, food or inhalants
- Infections e.g. chicken pox, influenza and TB
- Myeloproliferative neoplasms e.g. leukemia, essential thrombocythemia
What are the three different types of lymphocytes and what do they do?
- NK cells which function in cell-mediated cytotoxic innate immunity
- T cells which facilitate cell-mediated adaptive immunity
- B cells which facilitate humoral, antibody-driven adaptive immunity
What are the possible causes of lymphocytosis?
- In children – infection
- In the elderly patients – lymphoproliferative malignancies e.g. chronic lymphocytic leukaemia T- or NK- cell leukaemia and lymphomas
What is pancytopenia?
Pancytopenia is used to describe the condition where there is a reduction in the number of erythrocytes, leucocytes and platelets
Describe some possible causes of pancytopenia?
- Decreased production by bone marrow – B12/folate deficiency, malignancy or fibrosis, aplastic anaemia, drugs, viruses
- Increased splenic removal– hypersplenism, irradiation, drug insult, acute viral infection
How does pancytopenia present?
- Symptoms of anaemia (fatigue, dizziness, chest pain, SOB)
- Symptoms of thrombocytopenia (bleeding, bruising)
- Symptoms of neutropenia (infection, ulcers, fever)
- Symptoms of underlying disease condition